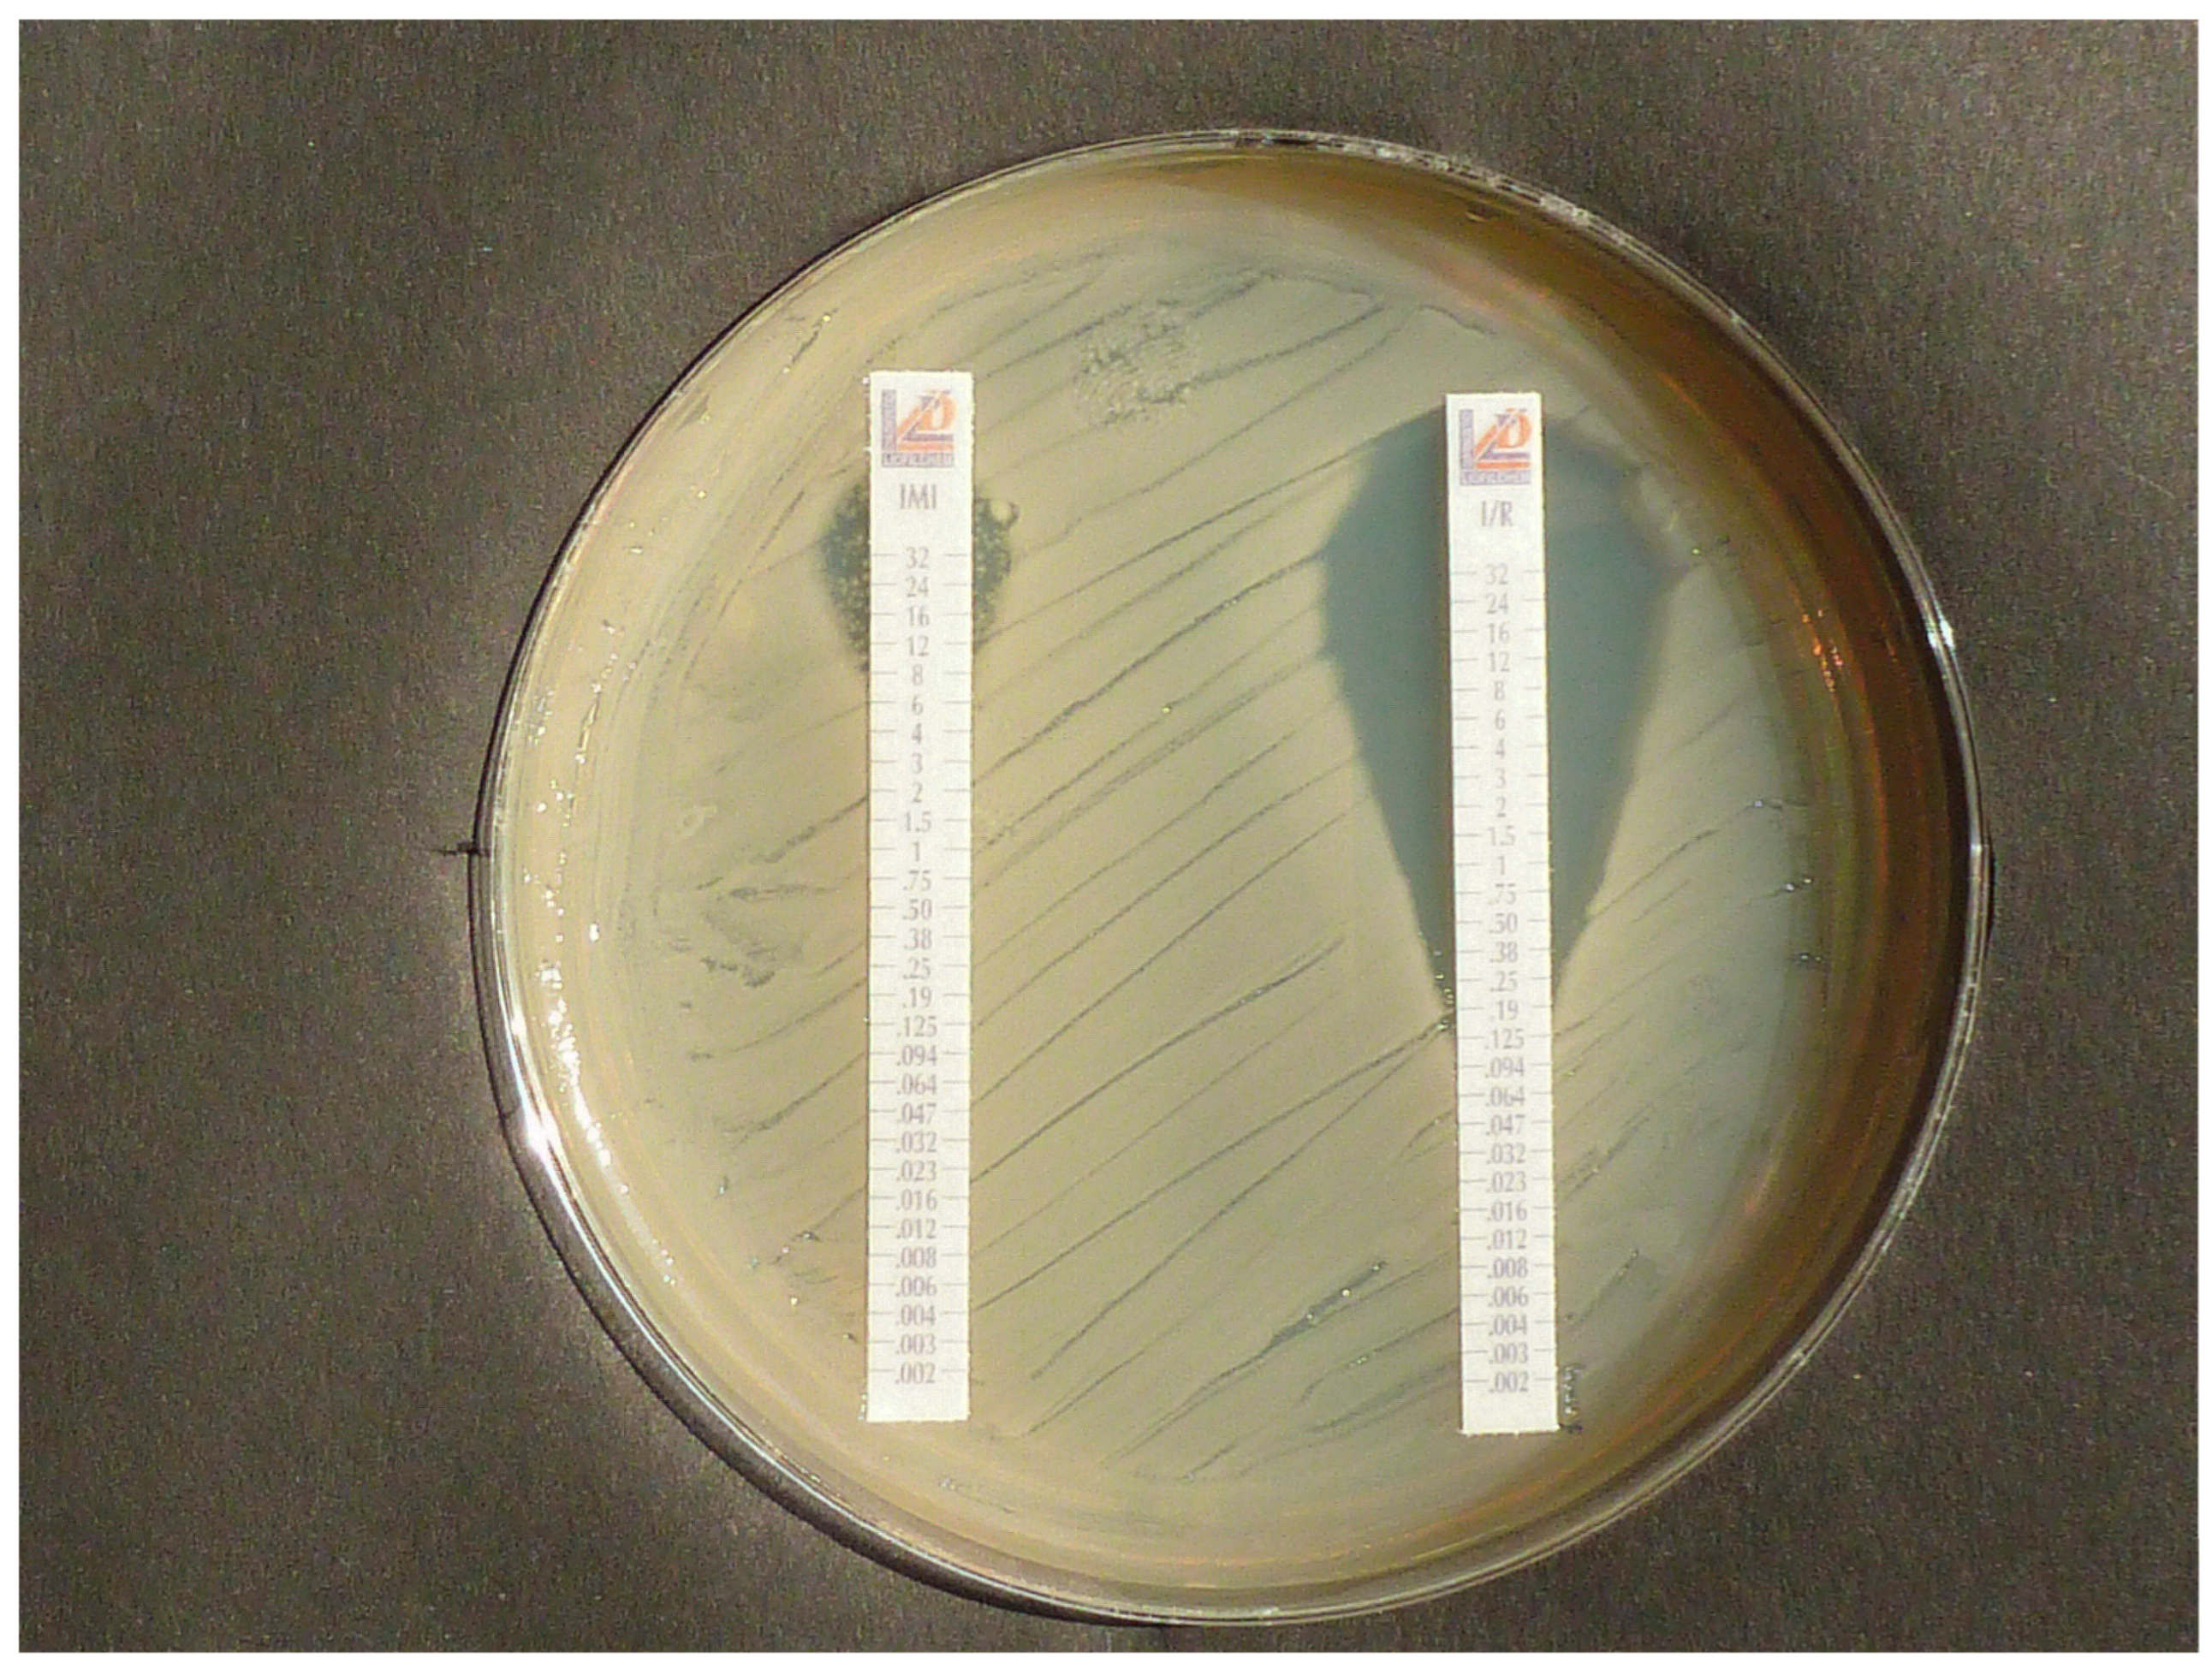
Diagnostics 15 02624 g001 Diagnostics 15 02624 g001

The Rapid CarbaLux Combination Test to Uncover Bacterial Resistance and Heteroresistance Prior to Antibiotic Treatment
Abstract
1. Introduction
1.1. Treatment of Infections by Combination Therapy
1.2. Current Methods for Detecting Carbapenemases and/or Bacterial Resistance
1.2.1. Molecular Assays
1.2.2. Lateral Flow Tests (LFTs)
1.2.3. The Carbapenemase Inactivation Method (CIM)
1.2.4. MIC Tests in Liquid Media and the Role of MALDI TOF MS
1.2.5. Agar Diffusion Susceptibility Tests
1.3. The Two CarbaLux Tests for Detecting Carbapenemases
1.3.1. The Classical CarbaLux Test for Carbapenemases
1.3.2. The New CarbaLux Combination Assay
2. Material and Methods
2.1. Bacterial Strains and Culturing
2.2. Materials and Preparation of Stock Solutions and Stability of Reagents for the CarbaLux Test
2.3. Measurement of Decay of Fluorescence
2.4. Protocols of the CarbaLux Combination Test
2.4.1. Test Without Pre-Exposure to Inhibitor
2.4.2. Assay with Pre-Exposure to the Inhibitor
2.5. Identification of Heteroresistant Isolates by Agar Diffusion Test
2.6. Identification of the Isolates by PCR and Lateral Flow Tests
2.7. Comparative Investigations by Lateral Flow Test and Agar Diffusion Test
3. Results
3.1. CarbaLux Test Results
3.2. Results from PCR and Lateral Flow Tests
3.3. Summarized Data from Standard Methods and the CarbaLux Tests
3.4. Features and Performance of Three Standard Methods and the CarbaLux Test
3.5. Proof of Heteroresistance and Results of Agar Diffusion Tests
4. Discussion
4.1. The Effect of Pre-Exposure to Avibactam
4.2. Comparison with Standard Test Methods
4.3. Advantage of the CarbaLux Tests in Clinical Decision Making
- Phenotypic tests enable the gross reactivity of bacterial enzymes to be assessed.
- They provide a clear yes/no answer regarding the presence or absence of carbapenemases and enable simple visual evaluation of the results.
- The fluorescence can also be easily read with photoelectronic devices. Therefore, the test methods could potentially be automated.
- The test results are available at least one day earlier than with growth-based assays.
- The tests can also identify suspicious heteroresistant bacteria.
- Metallo-beta-lactamases can be detected by inhibition with the PIC buffer or by exclusion of all serine beta-lactamases through pre-exposure of the bacteria to AVI.
- Bacteria from primary culture plates are examined as they are regularly used for further tests, including MIC tests.
- No expensive equipment is required. The tests work with a few micrograms of CF substrate. This makes the tests inexpensive and affordable even in low-income countries.
- Due to their high sensitivity, the tests can also identify bacteria that hyperproduce AmpC beta-lactamases, which inactivate clinical carbapenems, especially IPM.
- The classic CarbaLux test enables a decision for or against monotherapy with clinical carbapenems.
- The CarbaLux combination test enables a decision for or against combination therapy with carbapenemase inhibitors and carbapenems.
4.4. Sensitivity and Specificity of the Classical CarbaLux Test
4.5. Scope and Limitations
5. Conclusions
Author Contributions
Funding
Institutional Review Board Statement
Informed Consent Statement
Data Availability Statement
Acknowledgments
Conflicts of Interest
References
- Smith, R.; Coast, J. The true costs of antimicrobial resistance. BMJ 2013, 346, f1493. [Google Scholar] [CrossRef] [PubMed]
- Million Death Study Collaborators; Bassani, D.G.; Kumar, R.; Awasthi, S.; Morris, S.K.; Paul, V.K.; Shet, A.; Ram, U.; Gaffey MFBlack, R.E.; Jha, P. Causes of neonatal and child mortality in India: A nationally representative mortality survey. Lancet 2010, 376, 1853–1860. [Google Scholar] [CrossRef]
- Sands, K.; Carvalho, M.J.; Portal, E.; Thomson, K.; Dyer, C.; Akpulu, C.; Andrews, R.; Ferreira, A.; Gillespie, D.; Hender, T.; et al. Characterization of antimicrobial-resistant Gram-negative bacteria that cause neonatal sepsis in seven low- and middle-income countries. Nat. Microbiol. 2021, 6, 512–523. [Google Scholar] [CrossRef]
- Mukherjee, S.; Mitra, S.; Dutta, S.; Basu, S. Neonatal Sepsis: The Impact of Carbapenem-Resistant and Hypervirulent Klebsiella pneumoniae. Front. Med. 2021, 8, 634349. [Google Scholar] [CrossRef] [PubMed] [PubMed Central]
- Stein, C.; Zechel, M.; Spott, R.; Pletz, M.W.; Kipp, F. Multidrug-resistant isolates from Ukrainian patients in a German health facility: A genomic surveillance study focusing on antimicrobial resistance and bacterial relatedness. Infection 2023, 51, 1731–1738. [Google Scholar] [CrossRef] [PubMed] [PubMed Central]
- Higgins, P.G.; Hagen, R.M.; Podbielski, A.; Frickmann, H.; Warnke, P. Molecular Epidemiology of CarbapenemResistant Acinetobacter baumannii Isolated from War-Injured Patients from the Eastern Ukraine. Antibiotics 2020, 9, 579. [Google Scholar] [CrossRef] [PubMed] [PubMed Central]
- David, S.; Reuter, S.; Harris, S.R.; Glasner, C.; Feltwell, T.; Argimon, S.; Abudahab, K.; Goater, R.; Giani, T.; Errico, G.; et al. Epidemic of carbapenem-resistant Klebsiella pneumoniae in Europe is driven by nosocomial spread. Nat. Microbiol. 2019, 4, 1919–1929. [Google Scholar] [CrossRef] [PubMed] [PubMed Central]
- McConville, T.H.; Sullivan, S.B.; Gomez-Simmonds, A.; Whittier, S.; Uhlemann, A.-C. Carbapenem resistant Enterobacteriaceae colonization (CRE) and subsequent risk of infection and 90-day mortality in critically ill patients, an observational study. PLoS ONE 2017, 12, e0186195. [Google Scholar] [CrossRef] [PubMed] [PubMed Central]
- Hammoudi Halat, D.; Ayoub Moubareck, C. The Current Burden of Carbapenemases: Review of Significant Properties and Dissemination among Gram-Negative Bacteria. Antibiotics 2020, 9, 186. [Google Scholar] [CrossRef] [PubMed] [PubMed Central]
- Zavascki, A.P.; Falci, D.R.; da Silva, R.C.F.; Dalarosa, M.G.; Ribeiro, V.B.; Rozales, F.P.; Luz, D.I.; Magagnin, C.M.; Vieira, F.J.; Sampaio, J.M.; et al. Heteroresistance to carbapenems in New Delhi metallo-ßlactamase-1-producing isolates: A challenge for detection? Infect. Control. Hosp. Epidemiol. 2014, 35, 751–752. [Google Scholar] [CrossRef] [PubMed]
- Pournaras, S.; Ikonomidis, A.; Markogiannakis, A.; Maniatis, A.N.; Tsakris, A. Heteroresistance to carbapenems in Acinetobacter baumannii. J. Antimicrob. Chemother. 2005, 55, 1055–1056. [Google Scholar] [CrossRef] [PubMed]
- Xiong, Y.; Han, Y.; Zhao, Z.; Gao, W.; Ma, Y.; Jiang, S.; Wang, M.; Zhang, Q.; Zhou, Y.; Chen, Y. Impact of Carbapenem Heteroresistance Among Multidrug-Resistant ESBL/AmpC-Producing Klebsiella pneumoniae Clinical Isolates on Antibiotic Treatment in Experimentally Infected Mice. Infect. Drug Resist. 2021, 14, 5639–5650. [Google Scholar] [CrossRef] [PubMed Central]
- Fernández-Cuenca, F.; Gómez-Sánchez, M.; Rodríguez-Baño, J.; Martínez-Martínez, L.; Vila, J.; Bou, G.; Pascual, A. Epidemiological and clinical features associated with colonisation/infection by Acinetobacter baumannii with phenotypic heterogeneous resistance to carbapenems. Int. J. Antimicrob. Agents 2012, 40, 235–238. [Google Scholar] [CrossRef] [PubMed]
- Alexander, H.E.; Leidy, G. Mode of action of Streptomycin on type b H. influenzae: I. Origin of resistant organisms. J. Exp. Med. 1947, 85, 329–338. [Google Scholar] [CrossRef] [PubMed] [PubMed Central]
- Stojowska-Swędrzyńska, K.; Lupkowska, A.; Kuczyńska-Wiśnik, D.; Laskowska, E. Antibiotic Heteroresistance in Klebsiella pneumoniae. Int. J. Mol. Sci. 2021, 23, 449. [Google Scholar] [CrossRef] [PubMed] [PubMed Central]
- Band, V.I.; Weiss, D.S. Heteroresistance to beta-lactam antibiotics may often be a stage in the progression to antibiotic resistance. PLoS Biol. 2021, 19, e30001346. [Google Scholar] [CrossRef]
- Superti, S.V.; Martins, D.d.S.; Caierão, J.; Soares, F.d.S.; Prochnow, T.; Zavascki, A.P. Indications of carbapenem resistance evolution through heteroresistance as an intermediate stage in Acinetobacter baumannii after carbapenem administration. Rev. Do Inst. Med. Trop. São Paulo 2009, 51, 111–113. [Google Scholar] [CrossRef] [PubMed]
- Pournaras, S.; Kristo, I.; Vrioni, G.; Ikonomidis, A.; Poulou, A.; Petropoulou, D.; Tsakris, A. Characteristics of meropenem heteroresistance in Klebsiella pneumoniae carbapenemase (KPC)-producing clinical isolates of isolates of K. pneumoniae. J. Clin. Microbiol. 2010, 48, 2601–2604. [Google Scholar] [CrossRef] [PubMed]
- Nicoloff, H.; Hjort, K.; Levin, B.R.; Anderson, D.J. The high prevalence of antibiotic heteroresistance in pathogenic bacteria is mainly caused by gene amplification. Nat. Microbiol. 2019, 4, 504–514. [Google Scholar] [CrossRef]
- El-Halfawy, O.M.; Valvano, M.A. Antimicrobial heteroresistance: An emerging field in need of clarity. Clin. Microbiol. Rev. 2015, 28, 191–207. [Google Scholar] [CrossRef] [PubMed] [PubMed Central]
- Tamma, P.D.; Doi, Y.; Bonomo, R.A.; Johnson, J.K.; Simner, P.J.; Antibacterial Resistance Leadership Group. A Primer on AmpC β-Lactamases: Necessary Knowledge for an Increasingly Multidrug-resistant World. Clin. Infect. Dis. 2019, 69, 1446–1455. [Google Scholar] [CrossRef] [PubMed] [PubMed Central]
- Picot-Guéraud, R.; Batailler, P.; Caspar, Y.; Hennebique, A.; Mallaret, M.R. Bacteremia caused by multidrug resistant bacteria in a French university hospital center: 3 years of collection. Am. J. Infect. Control. 2015, 43, 960–964. [Google Scholar] [CrossRef] [PubMed]
- Goessens, W.H.; van der Bij, A.K.; van Boxtel, R.; Pitout, J.D.; van Ulsen, P.; Melles, D.C.; Tommassen, J. Antibiotic trapping by plasmid-encoded CMY-2 β-lactamase combined with reduced outer membrane permeability as a mechanism of carbapenem resistance in Escherichia coli. Antimicrob Agents Chemother. 2013, 57, 3941–3949. [Google Scholar] [CrossRef] [PubMed] [PubMed Central]
- Kuo, S.C.; Wang, Y.C.; Tan, M.C.; Huang, W.C.; Shiau, Y.R.; Wang, H.Y.; Lai, J.F.; Huang, I.W.; Lauderdale, T.L. In vitro activity of imipenem/relebactam, meropenem/vaborbactam, ceftazidime/avibactam, cefepime/zidebactam and other novel antibiotics against imipenem-non-susceptible Gram-negative bacilli from Taiwan. J. Antimicrob. Chemother. 2021, 76, 2071–2078. [Google Scholar] [CrossRef] [PubMed] [PubMed Central]
- Docquier, J.D.; Mangani, S. An update on β-lactamase inhibitor discovery and development. Drug Resist. Updates 2018, 36, 13–29. [Google Scholar] [CrossRef] [PubMed]
- Livermore, D.M.; Mushtaq, S.; Warner, M.; Vickers, A.; Woodford, N. In vitro activity of cefepime/zidebactam (WCK 5222) against Gram-negative bacteria. J. Antimicrob. Chemother. 2017, 72, 1373–1385. [Google Scholar] [CrossRef]
- Bonnin, R.A.; Bernabeu, S.; Emeraud, C.; Naas, T.; Girlich, D.; Jousset, A.B.; Dortet, L. In Vitro Activity of Imipenem-Relebactam, Meropenem-Vaborbactam, Ceftazidime-Avibactam and Comparators on Carbapenem-Resistant Non-Carbapenemase-Producing Enterobacterales. Antibiotics 2023, 12, 102. [Google Scholar] [CrossRef]
- Zhanel, G.G.; Lawrence, C.K.; Adam, H.; Schweizer, F.; Zelenitsky, S.; Zhanel, M.; Lagacé-Wiens, P.R.S.; Walkty, A.; Denisuik, A.; Golden, A.; et al. Imipenem-Relebactam and Meropenem-Vaborbactam: Two Novel Carbapenem-β-Lactamase Inhibitor Combinations. Drugs 2018, 78, 65–98, Erratum in Drugs 2018, 78, 787. https://doi.org/10.1007/s40265-018-0910-x. PMID: 29230684. [Google Scholar] [CrossRef] [PubMed]
- Maraki, S.; Mavromanolaki, V.E.; Magkafouraki, E.; Moraitis, P.; Stafylaki, D.; Kasimati, A.; Scoulica, E. Epidemiology and in vitro activity of ceftazidime-avibactam, meropenem-vaborbactam, imipenemrelebactam, eravacycline, plazomicin, and comparators against Greek carbapenemase-producing Klebsiella pneumoniae isolates. Infection 2022, 50, 467–474, Erratum in Infection 2022, 50, 1639. https://doi.org/10.1007/s15010-022-01918-4. [Google Scholar] [CrossRef] [PubMed]
- Bhagwat, S.S.; Periasamy, H.; Takalkar, S.S.; Palwe, S.R.; Khande, H.N.; Patel, M.V. The Novel β-Lactam Enhancer Zidebactam Augments the In Vivo Pharmacodynamic Activity of Cefepime in a Neutropenic Mouse Lung Acinetobacter baumannii Infection Model. Antimicrob. Agents Chemother. 2019, 63, e02146-18. [Google Scholar] [CrossRef] [PubMed] [PubMed Central]
- Chang, C.Y.; Lee, Y.L.; Huang, Y.T.; Ko, W.C.; Ho, M.W.; Hsueh, P.R. In vitro activity of imipenem/relebactam, meropenem/vaborbactam and comparators against Enterobacterales causing urinary tract infection in Taiwan: Results from the Study for Monitoring Antimicrobial Resistance Trends (SMART). Int. J. Antimicrob. Agents 2023, 61, 106815. [Google Scholar] [CrossRef]
- de León, S.R.; Daniels, K.; Clarke, A.J. Production and purification of the penicillin-binding protein 3 from Pseudomonas aeruginosa. Protein Expr. Purif. 2010, 73, 177–183. [Google Scholar] [CrossRef] [PubMed]
- Poirel, L.; Potron, A.; Nordmann, P. OXA-48-like carbapenemases: The phantom menace. J. Antimicrob. Chemother. 2012, 67, 1597–1606. [Google Scholar] [CrossRef] [PubMed]
- Jacobson, K.L.; Cohen, S.H.; Inciardi, J.F.; King, J.H.; Lippert, W.E.; Iglesias, T.; Van Couwenberghe, C.J. The relationship between antecedent antibiotic use and resistance to extended-spectrum cephalosporins in group I beta-lactamase-producing organisms. Clin. Infect. Dis. 1995, 21, 1107–1113. [Google Scholar] [CrossRef] [PubMed]
- Bush, K.; Fisher, J.F. Epidemiological expansion, structural studies, and clinical challenges of new βlactamases from Gram-negative bacteria. Annu. Rev. Microbiol. 2011, 65, 455–478. [Google Scholar] [CrossRef]
- Kaase, M.; Szabados, F.; Wassill, L.; Gatermann, S.G. Detection of carbapenemases in Enterobacteriaceae by a commercial multiplex PCR. J. Clin. Microbiol. 2012, 50, 3115–3118. [Google Scholar] [CrossRef] [PubMed] [PubMed Central]
- Thomson, K.S. Extended-spectrum-ß-lactamase, AmpC, and carbapenemase issues. J. Clin. Microbiol. 2010, 48, 109–1025. [Google Scholar] [CrossRef] [PubMed]
- Posthuma-Trumpie, G.A.; Korf, J.; Amerongen, A. Lateral flow (immuno)assay: Its strengths, weaknesses, 956 opportunities and threats. A literature survey. Anal. Bioanal. Chem. 2009, 393, 569–582. [Google Scholar] [CrossRef] [PubMed]
- Baeza, L.L.; Pfennigwerth, N.; Greissl, C.; Göttig, S.; Saleh, A.; Stelzer, Y.; Gatermann, S.G.; Hamprecht, A. Comparison of five methods for detection of carbapenemases in Enterobacterales with proposal of a new algorithm. Clin. Microbiol. Infect. 2019, 25, 1286.e9–1286.e15. [Google Scholar] [CrossRef] [PubMed]
- Mertins, S.; Higgins, P.G.; Thunissen, C.; Magein, H.; Gilleman, Q.; Mertens, P.; Rodríguez, M.G.; Maus, L.M.; Seifert, H.; Krönke, M.; et al. Development of an immunochromatographic lateral flow assay to rapidly detect OXA-23-, OXA-40-, OXA-58- and NDM-mediated carbapenem resistance determinants in Acinetobacter baumannii. J. Med. Microbiol. 2023, 72, 001681. [Google Scholar] [CrossRef] [PubMed]
- Philippon, A.; Arlet, G.; Labia, R.; Iorga, B.I. Class C β-Lactamases: Molecular Characteristics. Clin. Microbiol. Rev. 2022, 21, e0015021. [Google Scholar] [CrossRef] [PubMed] [PubMed Central]
- Hrabak, J.; Chudackova Papagiannitsis, C.C. Detection of carbapenemases in Enterobacteriaceae: A challenge for diagnostic microbiological laboratories. Clin. Microbiol. Infect. 2014, 20, 839–853. [Google Scholar] [CrossRef] [PubMed]
- van der Zwaluw, K.; de Haan, A.; Pluister, G.N.; Bootsma, H.J.; de Neeling, A.J.; Schouls, L.M. The Carbapenem Inactivation Method (CIM), a Simple and Low-Cost Alternative for the Carba NP Test to Assess Phenotypic Carbapenemase Activity in Gram-Negative Rods. PLoS ONE 2015, 10, e0123690. [Google Scholar] [CrossRef] [PubMed] [PubMed Central]
- Pierce, V.M.; Simner, P.J.; Lonsway, D.R.; Roe-Carpenter, D.E.; Johnson, J.K.; Brasso, W.B.; Bobenchik, A.M.; Lockett, Z.C.; Charnot-Katsikas, A.; Ferraro, M.J.; et al. Modified Carbapenem Inactivation Method for Phenotypic Detection of Carbapenemase Production among Enterobacteriaceae. J. Clin. Microbiol. 2017, 55, 2321–2333. [Google Scholar] [CrossRef] [PubMed] [PubMed Central]
- Sfeir, M.M.; Hayden, J.A.; Fauntleroy, K.A.; Mazur, C.; Johnson, J.K.; Simner, P.J.; Das, S.; Satlin, M.J.; Jenkins, S.G.; Westblade, L.F. EDTA-Modified Carbapenem Inactivation Method: Phenotypic Method for Detecting Metallo-β-Lactamase-Producing Enterobacteriaceae. J. Clin. Microbiol. 2019, 57, e01757-18. [Google Scholar] [CrossRef] [PubMed] [PubMed Central]
- Ramoul, A.; Loucif, L.; Bakour, S.; Amiri, S.; Dekhil, M.; Rolain, J.M. Co-occurrence of blaNDM-1 with blaOXA-23 or blaOXA-58 in clinical multidrug-resistant Acinetobacter baumannii isolates in Algeria. J. Glob. Antimicrob. Resist. 2016, 10, 136–141. [Google Scholar] [CrossRef]
- Pérez-Pérez, F.J.; Hanson, N. Detection of Plasmid-Mediated AmpC β-Lactamase Genes in Clinical Isolates by Using Multiplex PCR. J. Clin. Microbiol. 2002, 40, 2153–2162. [Google Scholar] [CrossRef] [PubMed] [PubMed Central]
- Bulik, C.C.; Fauntleroy, K.A.; Jenkins, S.G.; Abuali, M.; LaBombardi, V.J.; Nicolau, D.P.; Kuti, J.L. Comparison of meropenem MICs and susceptibilities for carbapenemase-producing Klebsiella pneumoniae isolates by various testing methods. J. Clin. Microbiol. 2010, 48, 2402–2406. [Google Scholar] [CrossRef] [PubMed] [PubMed Central]
- Lat, A.; Clock, S.A.; Wu, F.; Whittier, S.; Della-Latta, P.; Fauntleroy, K.; Jenkins, S.G.; Saisman, L.; Kubin, C.J. Comparison of Polymyxin B, Tigecycline, Cefepime, and Meropenem MICs for KPC-Producing Klebsiella pneumoniae by Broth Microdilution, Vitek 2, and Etest. J. Clin. Microbiol. 2011, 49, 1795–1798. [Google Scholar] [CrossRef] [PubMed] [PubMed Central]
- Singh-Moodley, A.; Perovic, O. Phenotypic and genotypic correlation of carbapenememase-producing Enterobacteriaceae and problems experienced in routine screening. S. Afr. Med. J. 2018, 108, 495–501. [Google Scholar] [CrossRef] [PubMed]
- Mimoz, O.; Grégoire, N.; Poirel, L.; Marliat, M.; Couet, W.; Nordmann, P. Broad-spectrum β-lactam antibiotics for treating experimental peritonitis in mice due to Klebsiella pneumoniae producing the carbapenemase OXA-48. Antimicrob. Agents Chemother. 2012, 56, 2759–2760. [Google Scholar] [CrossRef] [PubMed] [PubMed Central]
- Sherman, E.X.; Wozniak, J.E.; Weiss, D.S. Methods to Evaluate Colistin Heteroresistance in Acinetobacter baumannii. Methods Mol. Biol. 2019, 1946, 39–50. [Google Scholar] [CrossRef] [PubMed] [PubMed Central]
- Xu, L.; Mo, X.; Zhang, H.; Wan, F.; Luo, Q.; Xiao, Y. Epidemiology, mechanisms, and clinical impact of bacterial heteroresistance. npj Antimicrob. Resist. 2025, 3, 7. [Google Scholar] [CrossRef]
- Ikonomidis, A.; Neou, E.; Gogou, V.; Vrioni, G.; Tsakris, A.; Pournaras, S. Heteroresistance to meropenem in carbapenem-susceptible Acinetobacter baumannii. J. Clin. Microbiol. 2009, 47, 4055–4059. [Google Scholar] [CrossRef] [PubMed] [PubMed Central]
- Reiber, C.; Bodendoerfer, E.; Brugger, S.D.; Eberhard, N.; Hitz, E.; Hofmaenner, D.A.; Herren, S.; KolesnikGoldmann, N.; Manicini, S.; Zbinden, R.; et al. Rapid antimicrobial susceptibility testing in patients with bacteraemia due to Enterobacterales: An implementation study. Swiss Med. Wkly. 2023, 153, 40066. [Google Scholar] [CrossRef] [PubMed]
- Zurfluh, K.; Albini, S.; Mattmann, P.; Kindle, P.; Nüesch-Inderbinen, M.; Stephan, R.; Vogler, B.R. Antimicrobial resistant and extended-spectrum β-lactamase producing Escherichia coli in common wild bird species in Switzerland. MicrobiologyOpe 2019, 8, e845. [Google Scholar] [CrossRef] [PubMed] [PubMed Central]
- Pereira, C.; Larsson, J.; Hjort, K.; Elf, J.; Andersson, D.I. The highly dynamic nature of bacterial heteroresistance impairs its clinical detection. Commun. Biol. 2021, 4, 521. [Google Scholar] [CrossRef] [PubMed] [PubMed Central]
- EUCAST. The European Committee on Antimicrobial Susceptibility Testing. Breakpoint Tables for Interpretation of MICs and Zone Diameters. Version 15.0. 2025. Available online: https://www.eucast.org/fileadmin/src/media/PDFs/EUCAST_files/Breakpoint_tables/v_15.0_Breakpoint_Tables.pdf (accessed on 1 January 2025).
- Pfaendler, H.R.; Schmidt, H.-U.; Freidank, H. The Novel CarbaLux Test for Carbapenemases and Carbapenem Deactivating AmpC Beta-Lactamases. Front. Microbiol. 2020, 11, 588887. [Google Scholar] [CrossRef] [PubMed] [PubMed Central]
- Hudzicki, J. Kirby-Bauer Disk Diffusion Susceptibility Test Protocol 2016; American Society for Microbiology. Available online: https://asm.org/getattachment/2594ce26-bd44-47f6-8287-0657aa9185ad/Kirby-BauerDisk-Diffusion-Susceptibility-Test-Protocol-pdf (accessed on 8 December 2009).
- Coleman, K. Diazabicyclooctanes (DBOs): A potent new class of non-β-lactam β-lactamase inhibitors. Curr. Opin. Microbiol. 2011, 14, 550–555. [Google Scholar] [CrossRef] [PubMed]
- Bhowmick, T.; Weinstein, M.P. Microbiology of Meropenem-Vaborbactam: A Novel Carbapenem Beta-Lactamase Inhibitor Combination for Carbapenem-Resistant Enterobacterales Infections. Infect. Dis. Ther. 2020, 9, 757–767. [Google Scholar] [CrossRef] [PubMed] [PubMed Central]
- Livermore, D.M.; Canton, R.; Gniadkowski, M.; Nordmann, P.; Rossolini, G.M.; Arlet, G.; Ayala, J.; Coque, T.M.; Kern-Zdanowicz, I.; Luzzaro, F.; et al. CTX-M: Changing the face of ESBLs in Europe. J. Antimicrob. Chemother. 2007, 59, 165–174. [Google Scholar] [CrossRef] [PubMed]
- Queenan, A.M.; Shang, W.; Flamm, R.; Bush, K. Hydrolysis and inhibition profiles of beta-lactamases from molecular classes A to D with doripenem, imipenem, and meropenem. Antimicrob. Agents Chemother. 2010, 54, 565–569. [Google Scholar] [CrossRef] [PubMed] [PubMed Central]
- Walther-Rasmussen, J.; Høiby, N. OXA-type carbapenemases. J. Antimicrob. Chemother. 2006, 57, 373–383. [Google Scholar] [CrossRef] [PubMed]
- Ehmann, D.E.; Jahic, H.; Ross, P.L.; Gu, R.F.; Hu, J.; Durand-Réville, T.F.; Lahiri, S.; Thresher, J.; Livchak, S.; Gao, N.; et al. Kinetics of avibactam inhibition against Class A, C, and D βlactamases. J. Biol. Chem. 2013, 288, 27960–27971. [Google Scholar] [CrossRef] [PubMed] [PubMed Central]
- O’Callaghan, C.H.; Morris, A.; Kirby, S.M.; Shingler, A.H. Novel method for detection of beta-lactamases by using a chromogenic cephalosporin substrate. Antimicrob. Agents Chemother. 1972, 1, 283–288. [Google Scholar] [CrossRef] [PubMed] [PubMed Central]

| n | AVI | RELE | ZIDE | NACU | VABOR | CLX | PIC | Without Inhibitor | |
|---|---|---|---|---|---|---|---|---|---|
| Ratio inhibitor: CF | 3 | 3 | 3 | 3 | 3 | 10 | 150 | ||
| Type | |||||||||
| KPC | 2 | (2/2) | (2/2) | (1/2) | (1/2) | (2/2) | (0/2) | (0/2) | (0/2) |
| OXA-48 | 3 | (3/3) | (0/3) | (0/3) | (0/3)- | (0/3) | (0/3) | (0/3) | (0/3) |
| OXA-181 | 1 | (1/1) | (0/1) | (0/1) | (0/1)- | (0/1) | (0/1) | (0/1) | (0/1) |
| OXA-23 | 3 | (0/3) | (0/3) | (0/3) | (0/3) | (0/3) | (0/3) | (0/3) | (0/3) |
| OXA-40 | 1 | (0/1) | (0/1) | (0/1) | (0/1) | (0/1) | (0/1) | (0/1) | (0/1) |
| OXA-72 | 1 | (0/1) | (0/1) | (0/1) | (0/1) | (0/1) | (0/1) | (0/1) | (0/1) |
| AmpC hyperprod. | 4 | (4/4) | (2/4) | (3/4) | (4/4) | (0/4) | (4/4) | (0/4) | (0/4) |
| NDM | 1 | (0/1) | (0/1) | (0/1) | (0/1) | (0/1) | (0/1) | (1/1) | (0/1) |
| VIM | 1 | (0/1) | (0/1)- | (0/1) | (0/1) | (0/1) | (0/1) | (1/1) | (0/1) |
| OXA-23/NDM | 1 | (0/1) | (0/1) | (0/1) | (0/1) | (0/1) | (0/1) | (0/1) | (0/1) |
| ESBL | 2 | (2/2) | (2/2) | (2/2) | (2/2) | (2/2) | (2/2) | (2/2) | (2/2) |
| E. coli ATCC 25922 | 1 | (1/1) | (1/1) | (1/1) | (1/1) | (1/1) | (1/1) | (1/1) | (1/1) |
| n | Without Pre-Exposure to Avibactam | With Pre-Exposure to Avibactam for 15 min RT | ||
|---|---|---|---|---|
| Ratio Avibactam/CF | 1 | 3 | 1 | |
| Type | ||||
| KPC | 2 | (2/2) | (2/2) | (2/2) |
| OXA-48 | 3 | (0/3) | (3/3) | (3/3) |
| OXA-181 | 1 | (0/1) | (1/1) | (1/1) |
| OXA-23 | 3 | (0/3) | (0/3) | (3/3) |
| OXA-23/NDM | 1 | (0/1) | (0/1) | (0/1) 1 |
| OXA-40 | 1 | (0/1) | (0/1) | (1/1) |
| OXA-72 | 1 | (0/1) | (0/1) | (1/1) |
| AmpC hyperprod. | 4 | (3/4) | (4/4) | (4/4) |
| Isolate | PCR | Lateral Flow Tests CORIS RESIST-5 RESIST ACINETO | Disk Agar Diffusion Method, Inhibition Zone Diameter (mm) | CarbaLux Test with CF Time to Positive Result 1 | CarbaLux Inhibition Assay Time While Inhibition Remains Effective with 2 | |||||
|---|---|---|---|---|---|---|---|---|---|---|
| MEM * 10 µg | AVI 5 µg | MEM+AVI 10 + 5 µg | AVI/CF 3:1 | CLX/CF 10:1 | PIC/CF 150:1 | |||||
| 1. K. pneumoniae 2/2020 KPC | KPC+ | KPC+ | neg. | 10 SC | 11 CL | 19 CL | 1 min RT | >1 h 36 °C IN | 1 min RT NO | 1 min RT NO |
| 2. K. pneumoniae 6/2024 KPC | KPC+ | KPC+ | neg. | ≤6 | ≤6 | 16 SC | 1 min RT | >1 h 36 °C IN | 1 min RT NO | 1 min RT NO |
| 3. K. pneumoniae OXA-48 | OXA-48+ | OXA-48+ | neg. | 23 SC | 8 | 25 CL | 1 min RT | >1 h 36 °C IN | 1 min RT NO | 5 min RT NO |
| 4. K. pneumoniae OXA-181 | OXA-181+ | OXA-48+ | neg. | 23 SC | ≤6 | 24 CL | 3 min RT | >6 h 36 °C IN | 1 min RT NO | 1 min RT NO |
| 5. K. pneumoniae VIM | VIM+ | VIM+ | neg. | 15 SC | ≤6 | 15 SC | 1 min RT | 1 min RT NO | 1 min RT NO | >12 h 36 °C IN |
| 6. K. pneumoniae ESBL 2025 | neg. | neg. | neg. | 16 SC | ≤6 | 22 CL | >12 h 36 °C neg. result | >12 h 36 °C NO | >12 h 36 °C NO | >12 h 36 °C NO |
| 7. E. coli 573 OXA-48 | OXA-48+ | OXA-48+ | neg. | 22 CL | 10 | 24 CL | 1 min RT | >1 h 36 °C IN | 1 min RT NO | 1 min RT NO |
| 8. E. coli 3/2017 OXA-48 | OXA-48+ | OXA-48+ | neg. | 22 SC | 9 | 24 CL | 1 min RT | >1 h 36 °C IN | 1 min RT NO | 1 min RT NO |
| 9. E. coli NDM | NDM+ | NDM+ | NDM+ | 16 SC | 12 CL | 18 SC | 1 min RT | 1 min RT NO | 1 min RT NO | >12 h 36 °C IN |
| 10. E. coli ESBL 1 | neg. | neg. | neg. | 30 CL | 10 | 30 CL | >12 h 36 °C neg. result | >12 h 36 °C NO | >12 h 36 °C NO | >12 h 36 °C NO |
| 11. E. cloacae hyperprod. AmpC | neg. | neg. | neg. | 24 SC | ≤6 | 28 CL | 5 min RT | >2 h 36 °C IN | >6 h 36 °C IN | 15 min RT NO |
| 12. E. kobei hyperprod. AmpC | neg. | neg. | neg. | 24 SC | 10 | 28 CL | 1 min RT | >6 h 36 °C IN | >6 h 36 °C IN | 1 min RT NO |
| 13. E. ludwigii hyperprod. AmpC | neg. | neg. | neg. | ≤6 | 10 | 17 CL | 5 min 36 °C | >6 h 36 °C IN | >6 h 36 °C IN | 5 min 36 °C NO |
| 14. K. aerogenes 93 hyperprod. AmpC | neg. | neg. | neg. | 14 SC | ≤6 | 21 CL | 1 min RT | >6 h 36 °C IN | >6 h 36 °C IN | 1 min RT NO |
| 15. A. baumannii 42 OXA-23 | OXA-23+ | neg. | OXA-23+ | ≤6 | ≤6 | ≤6 | 15 min 36 °C | 15 min 36 °C NO | 5 min 36 °C NO | 15 min 36 °C NO |
| 16. A. baumannii 00 OXA-23 | OXA-23+ | neg. | OXA-23+ | 8 | 10 | 12 SC | 15 min RT | 15 min RT NO | 15 min RT NO | 15 min RT NO |
| 17. A. baumannii 90 OXA-23 | OXA-23+ | neg. | OXA-23+ | ≤6 | ≤6 | ≤6 | 15 min RT | 15 min RT NO | 15 min RT NO | 15 min RT NO |
| 18. A. baumannii OXA-40 | OXA-40+ | neg. | OXA-40/58+ | ≤6 | ≤6 | ≤6 | 15 min RT | 15 min RT NO | 5 min RT NO | 5 min RT NO |
| 19. A. baumannii OXA-72 | OXA-72+ | neg. | OXA-40/58+ weak signal | ≤6 | ≤6 | ≤6 | 5 min 36 °C | 5 min 36 °C NO | 5 min 36 °C NO | 5 min 36 °C NO |
| 20. A. baumannii OXA-23/NDM | OXA- 23+NDM+ | NDM+ | OXA 23+ NDM+ | ≤6 | ≤6 | ≤6 | 15 min RT | 15 min 36 °C NO | 15 min RT NO | 15 min RT NO |
| E. coli ATCC 25922 (reference strain.) | n.d. | n.d. | n.d. | 29 CL | 9 | 29 CL | >24 h 36 °C neg. result | >24 h 36 °C NO | >24 h 36 °C NO | >24 h 36 °C NO |
| Features | Methods | ||||||
|---|---|---|---|---|---|---|---|
| PCR | Automated Broth Dilution | Lateral Flow Test | Disk Agar Diffusion | Carbapenem Inactivation Method CIM | CarbaLux Test | CarbaLux Test with Inhibitor | |
| Identification of species required for result | no | yes | no/yes 1 | yes * | no | no | no |
| Detection of heteroresistance | yes | no | yes | yes 2 | yes | yes | yes |
| Detection of hyperproduced AmpC beta-lactamases | no | no | no | yes 2 | yes | yes | yes |
| Detection of all carbapenemases | no | no ** | no | no ** | yes | yes | no |
| Identification of carbapenemase-type | yes, when addressed | no | yes, when addressed | no | no | no | yes |
| Semiquantitative assessment of carbapenemase activity | no | no | no | no | yes | yes | yes |
| Allows direct isolate-specific conclusion for mono therapy | no | only with full resistance | no | yes | yes | yes | no |
| Allows direct isolate-specific conclusion for combination therapy | no | no | no | yes 2 | no | no | yes |
| Manual handling time | 5–10 min | 3–5 min | 5–10 min, two sets | 20–30 min | 60 min | 3 min | 3 min |
| Time to result 3 | 1–4 h | 12–18 h | 15 min | 18 h | 30 h | 1–30 min | 15–60 min |
| Suitable as initial test | no | yes | no | yes | no | yes | yes |
| Suitable for automated performance | yes | yes | no | no | no | yes | yes |
| Approximate cost per test unit (EUR) | 30 | 5–10 | 15 + 15 1 | 2 | 2 | 4 | 4 |
| Approximate cost for special equipment 4 (EUR) | 12,000 | 40,000 | 0 | 0 | 0 | 0 | 0 |
| Approximate cost for MALDI TOF MS for species identification. 4 (cost for device and cost for single ID, EUR) | not required | 200,000 1-2/ID | 200,000 1-2/ID | 200,000 1-2/ID | not required for result | not required for result | not required for result |
Disclaimer/Publisher’s Note: The statements, opinions and data contained in all publications are solely those of the individual author(s) and contributor(s) and not of MDPI and/or the editor(s). MDPI and/or the editor(s) disclaim responsibility for any injury to people or property resulting from any ideas, methods, instructions or products referred to in the content. |
© 2025 by the authors. Licensee MDPI, Basel, Switzerland. This article is an open access article distributed under the terms and conditions of the Creative Commons Attribution (CC BY) license (https://creativecommons.org/licenses/by/4.0/).
Share and Cite
Pfaendler, H.R.; Schmidt, H.-U. The Rapid CarbaLux Combination Test to Uncover Bacterial Resistance and Heteroresistance Prior to Antibiotic Treatment. Diagnostics 2025, 15, 2624. https://doi.org/10.3390/diagnostics15202624
Pfaendler HR, Schmidt H-U. The Rapid CarbaLux Combination Test to Uncover Bacterial Resistance and Heteroresistance Prior to Antibiotic Treatment. Diagnostics. 2025; 15(20):2624. https://doi.org/10.3390/diagnostics15202624
Chicago/Turabian StylePfaendler, Hans Rudolf, and Hans-Ulrich Schmidt. 2025. "The Rapid CarbaLux Combination Test to Uncover Bacterial Resistance and Heteroresistance Prior to Antibiotic Treatment" Diagnostics 15, no. 20: 2624. https://doi.org/10.3390/diagnostics15202624
APA StylePfaendler, H. R., & Schmidt, H.-U. (2025). The Rapid CarbaLux Combination Test to Uncover Bacterial Resistance and Heteroresistance Prior to Antibiotic Treatment. Diagnostics, 15(20), 2624. https://doi.org/10.3390/diagnostics15202624

